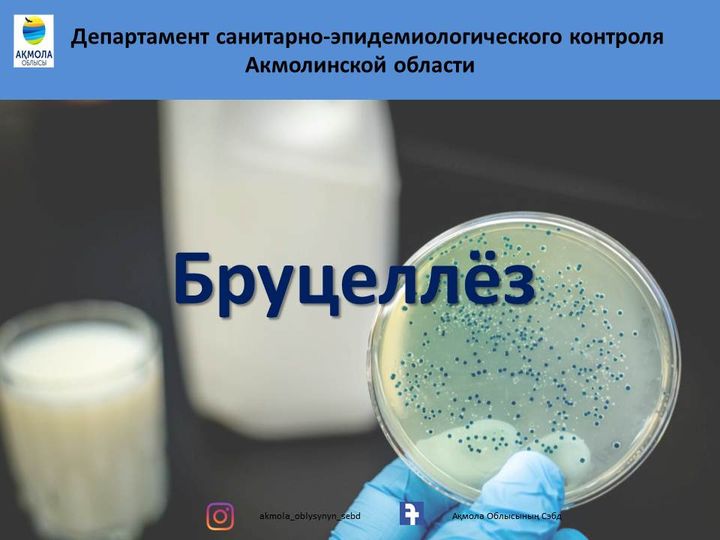
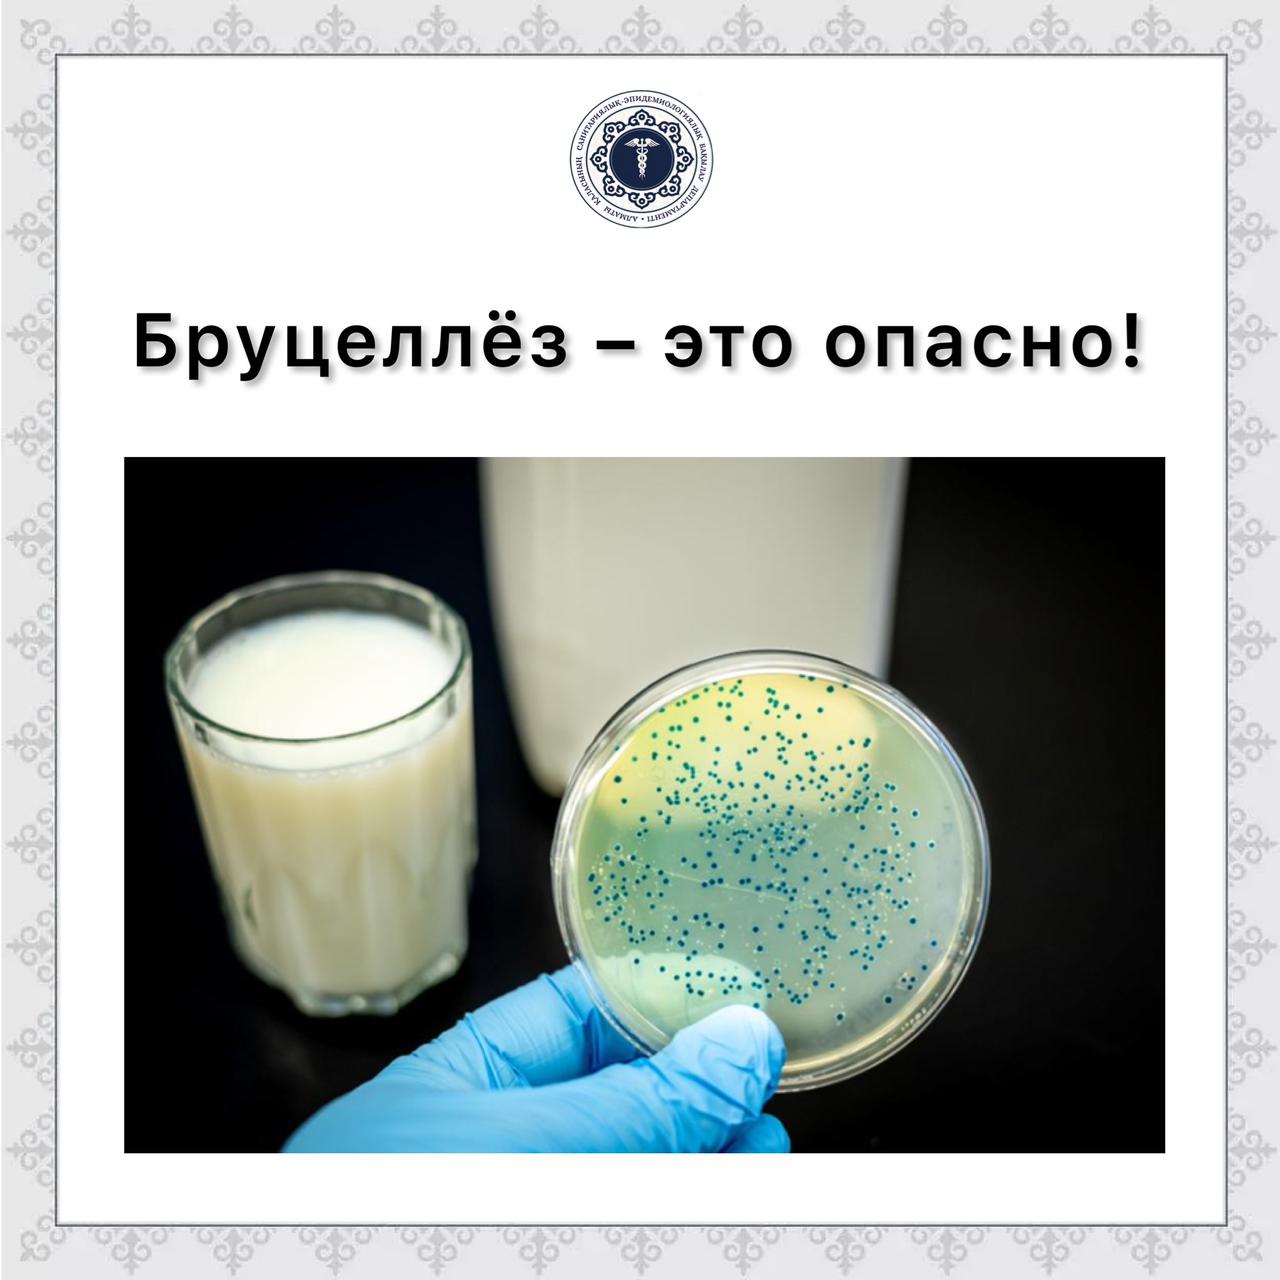

Бруцеллез рск
Бруцеллез рск 115 фото
Как часто ставят от столбняка
Мк пак 2
Клянусь в романе была гендерная
Прохождение we were here expeditions the friendship
Гид 100
Магазин находка нижнекамск
Нежными теперь как мне быть
Метро киевская синяя
Генконсульство в шанхае
Как часто поливать хамедорею